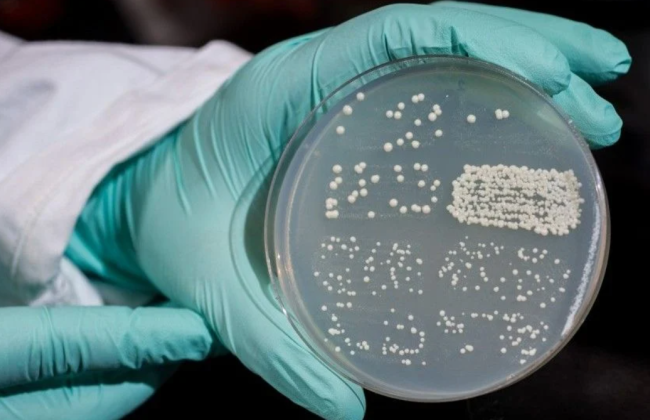
После коронавируса по миру стремительно распространяется новая смертельная угроза — грибковые инфекции

После коронавируса по миру стремительно распространяется новая смертельная угроза — грибковые инфекции
В результате пандемии коронавируса и изменения климата в мире наблюдается вспышка редких грибковых заболеваний. Об этом сообщает Bloomberg.
Стремительное потепление помогло заболеваниям научиться преодолевать естественную защиту человека – температуру тела.
Издание указывает, что легкие грибковые заболевания стали привычными – к ним относится перхоть. А вот заболевания, вызванные грибком Candida auris, часто поражающим людей со слабой иммунной системой, встречаются гораздо реже — но этот грибок убивает до половины инфицированных.
Грибок Candida auris сейчас находится на всех континентах, кроме Антарктиды. Грибки, вызывающие тяжелые заболевания, также начали поражать и молодых здоровых людей – это свидетельствует о растущей силе патогенов.
Хотя количество зарегистрированных случаев заболеваний, вызванных смертельными грибками, все еще невелико, по сравнению с другими болезнями, темпы их распространения за последние несколько лет вызывают беспокойство, как и тот факт, что мутации делают их более устойчивыми к лечению. Миллионы случаев также остаются незарегистрированными, поскольку возбудители играют опосредованную роль в смерти людей от рака до ВИЧ-инфекции.
Впервые грибок Candida auris был найден в ушном канале пациента в Японии в 2009 году. Но уже в 2022 году это последний год, за который есть исчерпывающие данные, в США этот грибок нашли у 2 377 человек. Это более чем в семь раз больше, чем в 2018 году — именно тогда решили, что о заболевании грибком нужно сообщать в органы здоровья.
«Люди знают о грибках на ногтях ног, но они не задумываются о том, что грибки все чаще вызывают опасные для жизни человека заболевания. Мир только начинает осознавать необходимость более точной и быстрой диагностики грибковых инфекций у людей», — отметила профессор Сара Гурр, специализирующаяся на грибковых инфекциях в Университете Эксетера.
Также отмечается, что рост глобальной температуры также способствует адаптации грибков к более теплой среде, а последствия пандемии, в частности переполненные больницы, влажная среда и длительное использование оборудования, только усугубили ситуацию.
Сообщается, что в 2021 году в больницах Индии после пандемии COVID-19 обнаружили мукормикоз или черный грибок, распространившийся через системы для кислорода, пораженные плесенью.
Чтобы снизить риск заражения грибами, такими как Candida auris, важно соблюдать профилактические меры, особенно в медицинских учреждениях, где инфекция передается наиболее часто.
Центр по контролю и профилактике заболеваний США (CDC) и британское Министерство здравоохранения (PHE) советуют соблюдать несколько простых правил:
- Следить за гигиеной рук.
- Дезинфицировать помещение и оборудование, поскольку грибок может оставаться на поверхностях в течение нескольких недель. Этот совет особенно касается медицинских учреждений.
- Инфицированные пациенты должны находиться в отдельных палатах или помещениях во избежание перекрестного заражения.
- В больницах рекомендуется проводить регулярный скрининг пациентов с высоким риском заражения (например, пациентов, часто находящихся в медицинских учреждениях или проходящих лечение за границей).
Подписывайтесь на наш Тelegram-канал t.me/sudua и на Google Новости SUD.UA, а также на наш VIBER, страницу в Facebook и в Instagram, чтобы быть в курсе самых важных событий.







































